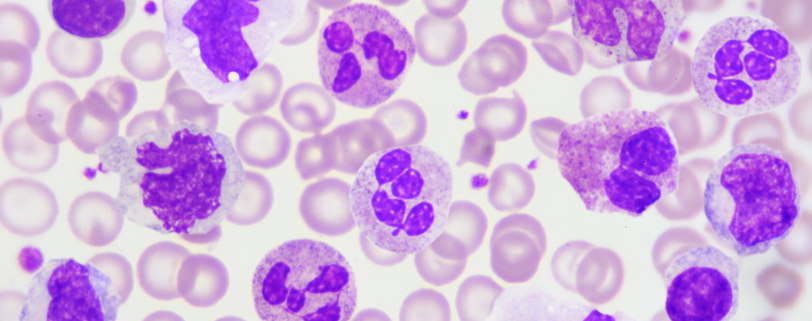

First amniotic fluid-derived human organoids will advance prenatal precision medicine in a new era.
Researchers created 3D models of developing organs from fetal cells, which are present in amniotic fluid, to help prenatal diagnosis and speed up innovative therapeutic strategies in rare diseases. Congenital disorders, according to WHO (World Health Organization), affect 6% of newborns globally, ca...